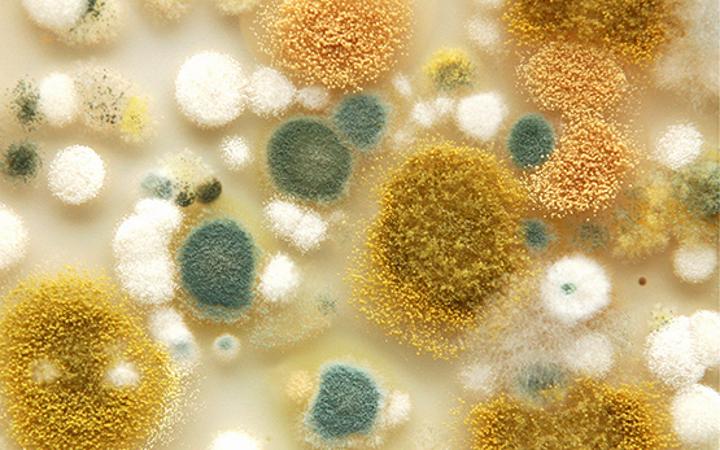

Africa-Press – Congo Kinshasa. Une étude de l’Organisation mondiale de la santé (OMS) datée de 2019, atteste que, si le monde ne prend garde, 10 millions de vies par an seront perdus, associées à un coût cumulatif estimé à 100.000 mille milliards de dollars américains à cause de la propagation de la Résistance aux antimicrobiens (RAM).
Celle-ci constitue en effet, un problème multisectoriel d’ampleur mondiale qui menace la vie de millions de personnes dans le monde et met en danger les économies de plusieurs pays dans tous les continents.
En raison de ces conséquences graves sur les plans médical et économique, il paraît nécessaire de faire le suivi de la RAM et de veiller à la bonne utilisation des antimicrobiens.
Sources de la Résistance aux antimicrobiens
La Résistance aux antimicrobiens (RAM) est occasionnée par la pression sélective naturelle et résulte des actions humaines telles que l’utilisation inappropriée des antimicrobiens dans le secteur de la santé, la production animale, l’agriculture et l’environnement.
Cette utilisation inadéquate est favorisée par des facteurs comme l’absence ou la non-application de la réglementation, le mauvais suivi du traitement recommandé par les agents de santé et l’utilisation des antimicrobiens en production animale comme aliments médicamenteux.
Dans le même ordre d’idées, la vente au comptoir pharmaceutique sans prescription médicale et la disponibilité d’antimicrobiens contrefaits, contribuent à empirer le phénomène. En outre, la RAM rend le traitement de certaines infections inefficaces, entraînant une mortalité accrue, des maladies plus graves ou prolongées, des pertes de productions ainsi que des problèmes de sécurité sanitaire des aliments.
A savoir
Les États membres de l’OMS ont retenu la sécurité sanitaire, y compris la résistance aux antimicrobiens (RAM), comme l’une des priorités des actions à mener par cette organisation du système des Nations Unies, au cours des années à venir. Car non seulement la RAM risque de réduire à néant les résultats acquis dans le domaine de la santé sur l’échelle mondiale, mais elle met également en péril les futurs progrès sanitaires sur plusieurs fronts. Elle menace également les avancées obtenues dans le domaine de la santé publique, notamment en matière de lutte contre la tuberculose, le paludisme, le VIH/Sida, les Maladies sexuellement transmissibles (MST)…
Pour rappel, la Resistance aux antimicrobiens s’applique spécifiquement aux bactéries qui deviennent résistantes aux antibiotiques. Les personnes les plus touchées sont des populations pauvres et vulnérables, c’est-à-dire, celles qui éprouvent des difficultés pour se procurer des antibiotiques efficaces.




